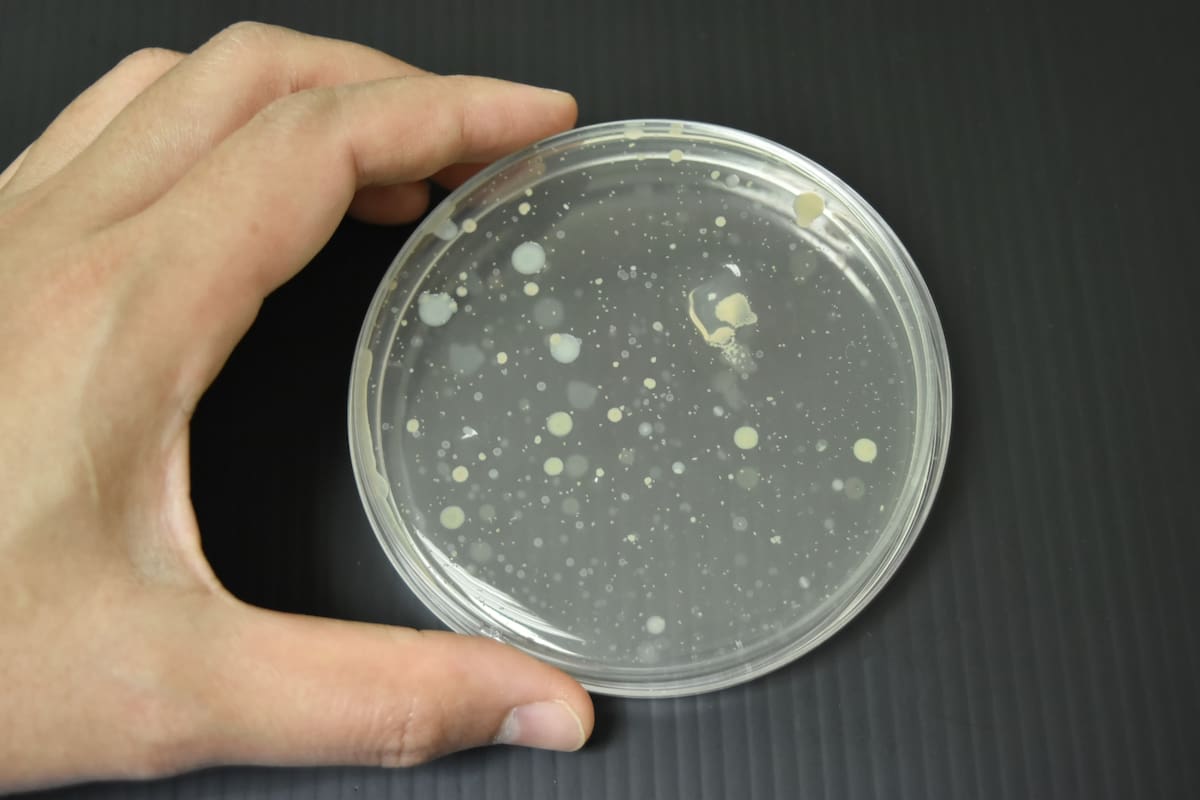

Lockie, padre de 20 años, fallece por una pequeña ampolla en el labio que luego le afectó el cerebro
La bacteria es la causa principal del 60% de las infecciones purulentas agudas en el mundo.
AUSTRALIA.- Lockie Seddon, un joven padre australiano de 20 años, que perdió la vida luego de una infección por la bacteria Staphylococcus aureus, conocida como estafilococo dorado, tras cortarse el labio.
Según declaraciones de sus seres queridos a medios como news.com.au, Herald Sun y Daily Mail Australia, Lockie desarrolló una pequeña ampolla en el labio que rápidamente se agravó, afectando su cerebro.
Lockie era padre de dos niños pequeños, Mason, de 3 años, y Jax, de 2, y esperaba junto a su pareja, Claire, el nacimiento de su tercera hija.
“Él era un padre amoroso y entregado”, señala una publicación en una cuenta de GoFundMe creada para apoyar a la familia en estos difíciles momentos. “Todos los que conocían a Lockie lo amaban. Deja muchos corazones rotos y maravillosos recuerdos”.
El rápido avance de la infección
Según su tía, Danielle Sherer, Lockie comenzó a quejarse de un dolor extremo días después de que la lesión apareció en su labio. Fue llevado al hospital, donde los médicos lo colocaron en un coma inducido en un intento desesperado por salvarlo.
“Lamentablemente, nunca despertó”, declaró Sherer. Los doctores confirmaron que era “demasiado tarde” para revertir el daño causado por la bacteria, que había alcanzado su cerebro.
Un llamado a la conciencia
La tragedia ha servido como un recordatorio de los riesgos de infecciones bacterianas y la importancia de buscar atención médica ante cualquier síntoma preocupante.
Según Lifeder, Staphylococcus aureus es la especie del género Staphylococcus más patógena.
Te puede interesar: Conan, conoce la bacteria que puede aguantar la radiación extrema
Es la causa principal del 60% de las infecciones purulentas agudas en el mundo.
Explican que si las lesiones se extienden y confluyen se forman lesiones llamadas ántrax.
Se pueden agravar y el microorganismo puede invadir el torrente sanguíneo.
Sigue nuestro canal de WhatsApp
Recibe las noticias más importantes del día. Da click aquí
Te recomendamos

Joven fingió enfermedad mental para evadir servicio militar: Tribunal Supremo confirma condena por engaño y lo sentencia a prisión suspendida

Primer caso humano de gripe aviar H5N5 en el mundo fallece; autoridades refuerzan vigilancia sanitaria

Científicos de la UNAM descubren en Oaxaca un “ejército” de bacterias benéficas con potencial para recuperar suelos agrícolas, reducir agroquímicos y fortalecer la agricultura sostenible en México

Temporada de influenza: cómo cuidarte en casa, en el trabajo y en espacios públicos

Grupo Healy © Copyright Impresora y Editorial S.A. de C.V. Todos los derechos reservados